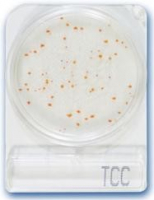
compact_dry_tcc_tea_es_catechin_teszt.jpg
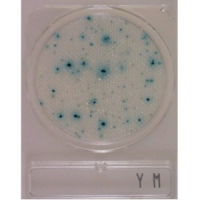
compact_dry_ym_eleszto_es_penesz_mikrobiologiai_teszt.jpg

Részletes információk
Compact Dry tesztek dehidratált, száraz táptalajok, melyek különböző mikroorganizmusok kimutatására alkalmasak folyékony és szilárd mintákból.
A NISSUI Pharmacutical Co. Ltd által gyártott és a HyServe GmbH által forgalmazott, Compact Dry tesztek dehidratált, száraz táptalajok, melyek különböző mikroorganizmusok kimutatására alkalmasak folyékony és szilárd mintákból. A tesztek előnye, hogy csökkentik a mikroorganizmusok kimutatására, számlálására fordított időt. A teszt plate-k egyformán használhatóak mind a nyersanyagok, mind pedig a végtermékek vizsgálatához az élelmiszer, üdítőital-, hús- és kozmetikai ipar területén illetve higiéniai laboratóriumokban.
A plate-n lévő táptalaj kromogén anyagot és redoxi indikátort tartalmaz. Az inkubálást követően a kinövő telepek színesek és az adott mikroorganizmusra jellemzőek. A specifikus táptalajon a mikroorganizmusok azonosítása szín alapján történik. A plate-k szobahőmérsékleten tárolhatók, fajtától függően 1 – 2 évig. Az alkalmazott inkubációs idő 20 – 43 °C között változik.
A teszt plate-k tulajdonképpen fedéllel ellátott műanyag tálkák, melyeknek az alján a táptalaj dehidratált formában van jelen egy gézszerű hálón. A vizsgálat 1 ml minta anyagot igényel, mely a plate alján egyenletesen szétterül. A fedél vizsgálat előtt és során megvédi a táptalajt a nemkívánatos szennyezéstől. A plate-k külső, alsó részén 0.5 cm-es karcolt négyzethálós rácsozat található, mely megkönnyíti a telepszámlálást.
Nemcsak folyékony minták, hanem szilárd illetve száraz, szilárd felületről vett minták is vizsgálhatók. A szilárd mintát először egy puffer oldattal homogenizálni, majd, ha szükséges szűrni és hígítani kell. Szilárd felületről az un Compact Dry Swab segítségével vesszük a mintát.
Erős fertőzöttség esetén az értékelhető vizsgálathoz hígítási sorozatot kell alkalmazni. Egy négy tagból álló sorozat a forgalmazótól szintén beszerezhető. Az egyes hígító edénykék 9 ml steril NaCl Pepton puffer oldatot tartalmaznak. A hígítási sorozat felhasználásával szükség esetén így bármekkora hígítás is elérhető.
A Plate-k háromrétegű alumínium fólia tasakba (műanyag + alumínium + műanyag) vannak csomagolva. A plate-k validálását a NordVal/NMKL végezte. Így a HACCP előírásait követő rendszerekben is biztonsággal használható.
Általános jellemzői a Compact Dry TCC-nek :
- A plate egy egyedülálló Catechin ínaktivációs rendszer, mely lehetővé teszi azon baktériumok és spórák kimutatását, melyek normál standard táptalajon nem kimutathatóak.
- A teát vagy catechint tartalmazó élelmiszerekben, ezek antibakteriális és gombaőlő hatása miatt a fertőző mikroorganizmusok kimutatása nem lehetséges a hagyományos eljárással.
- Ezen segít az újonnan kifejlesztett Compact Dry TCC.
| Típus: | Rendelési szám: | Csomagolási egység: | Alkalmazás: |
| Compact Dry TCC | 1 006 732 | 40 plate | Tea termékek össz csíra-száma: catechin inaktivá-torral |
| 1 006 731 | 240 plate |